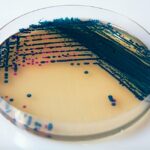
CHROMOGENE STREPTO B Boite90

CHROMOGENE STREPTO B (100ML)
Réservé aux pros

CHROMOGENE STREPTO B Boite90
Réservé aux pros

CHROMOGENE STREPTO B (100ML)
Réservé aux pros
CHROMOGENE STREPTO B Boite90
Réservé aux pros
CHROMOGENE STREPTO B (200ML)
Livraison sur toute la Tunisie
Produit certifié et de qualité
Livraison estimée: 17/04/2026 – 20/04/2026
UGS :
G0462
Catégorie : Milieux de cultures
💬
Besoin d’un devis ou d’un conseil ?
Vous avez besoin d’un devis, d’un conseil ou d’une commande en quantité ? Contactez notre équipe au +216 58 994 441 ou via WhatsApp.






